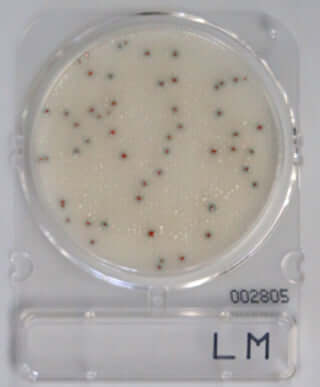
Compact Dry LM

Food Safety Tests
Food Safety Tests to testing What comes in (Raw materials), and what goes out (end product) of your plant. Mycotoxins (R-Biopharm).
Showing 1 - 17 of 17 products
Display
View


Kormay Biomedicals store
Easy Plate AC (Film medium for general viable bacterial count)
Sale price$245.00 CAD


Kormay Biomedicals store
Easy Plate SA (Film medium for Staphylococcus aureus count)
Sale price$285.00 CAD
Filters (0)